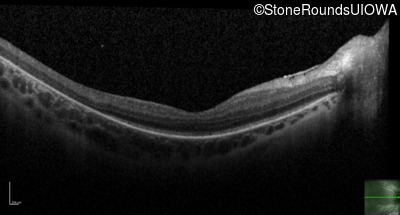
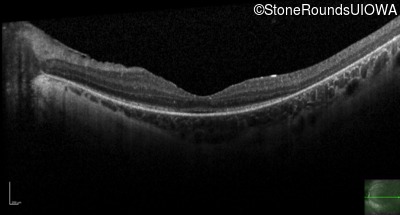

Case
SR88
Student Mode
SECORD (IA2b)
Female
Female
Hidden
SR88
Student Mode
SECORD (IA2b)
Female
Female
Highlighted Images
| Age at visit: 16 years | OD | OS |
|---|---|
History
This 16 year old female has had poor visual acuity and poor vision in dim light for most of her life. She has normal hearing and no cognitive difficulties.
| Age at visit: 16 years |
| OD | OS | ||
|---|---|---|---|
| OD | OS | ||
|---|---|---|---|
| OD | OS | ||
|---|---|---|---|
| OD | OS | ||
|---|---|---|---|